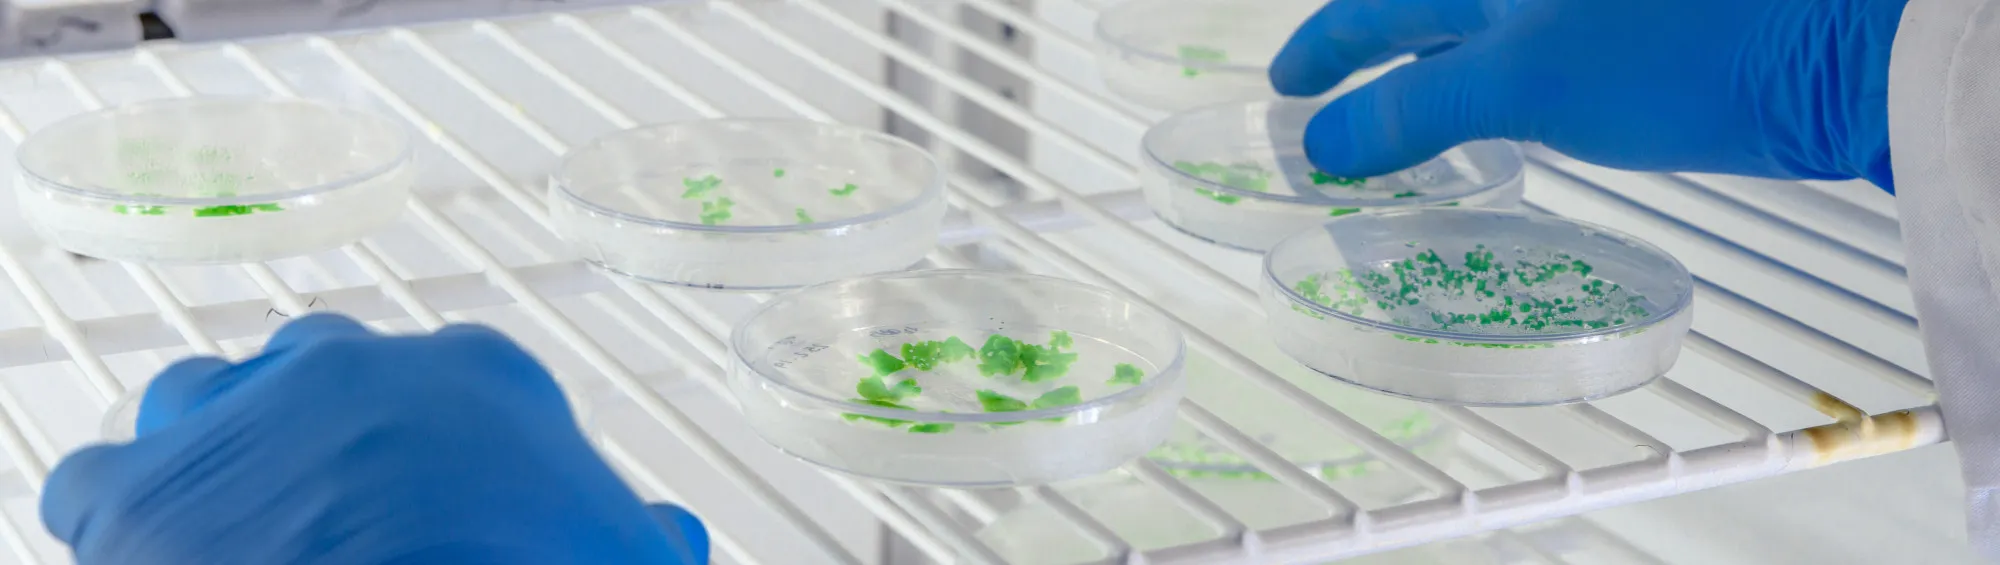

Antibacterial / Antimicrobial Testing Services
Textile, plastic
Microbium provides specialized testing to evaluate the antimicrobial properties of textiles, plastics, and paints, ensuring they meet industry standards and regulatory requirements.
Textile
We test textile materials for antimicrobial properties using internationally recognized methods:

Antibacterial
- ISO 20743:2021 Textiles – Determination of antibacterial activity of textile products.
- AATCC 100 – Antibacterial finishes on textile materials – Assessment of antibacterial activity.
Antifungal
- AATCC 100– Antifungal testing of textiles – Evaluating fungal resistance of textile materials.
Plastic
To ensure plastics have effective antimicrobial properties, we perform:

Antifungal
- ASTM D3273 – Standard test method for resistance of plastic materials to fungal growth.
Paints & Coatings
For paints and coatings, we offer:

- ASTM D4783 – Standard test method for resistance of paints and coatings to microbial growth.
Our comprehensive testing services ensure your materials are resistant to microbial contamination and meet market demands.
Frequently Asked Questions
How long does antimicrobial testing take?
Textile testing – Typically 7-10 days depending on the method. Plastic testing – Ranges from 7-14 days based on the required standard. Paints testing – Generally 10-14 days for microbial resistance evaluation.
Ready to take the next step?
